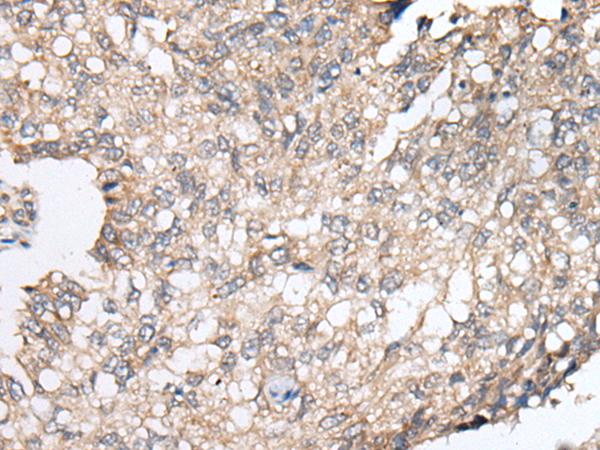

中文名稱:兔抗BRI3BP多克隆抗體
|
Background: |
BRI3BP (BRI3 binding protein), also known as BNAS1, HCCR-1, I3-binding protein or cervical cancer 1 proto-oncogene-binding protein KG19, is a 251 amino acid multi-pass membrane protein. Though widely expressed, BRI3BP is found at highest levels in brain, kidney and liver where it localizes to the endoplasmic reticulum (ER) and is involved in ER structural dynamics and mitochondrial viability. Possessing pro-apoptotic properties and the ability to potentiate drug-induced apoptosis, BRI3BP overexpression has been shown to enhance caspase-3 and mitochondrial cytochrome c release in etoposide-treated human embryonic kidney 293T cells. |
|
Applications: |
ELISA, WB, IHC |
|
Name of antibody: |
BRI3BP |
|
Immunogen: |
Synthetic peptide of human BRI3BP |
|
Full name: |
BRI3 binding protein |
|
Synonyms: |
KG19; BNAS1; HCCR-1; HCCR-2; HCCRBP-1 |
|
SwissProt: |
Q8WY22 |
|
ELISA Recommended dilution: |
5000-10000 |
|
IHC positive control: |
Human lung cancer and human tonsil |
|
IHC Recommend dilution: |
25-100 |
|
WB Predicted band size: |
28 kDa |
|
WB Positive control: |
K562 cell,Mouse brain tissue and RAW264.7 cell |
|
WB Recommended dilution: |
200-1000 |

購物車
幫助
021-54845833/15800441009
